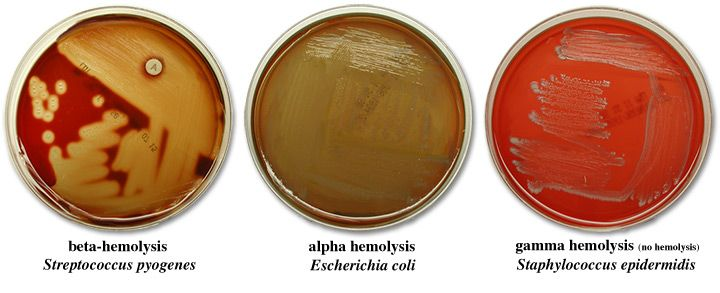
<p>no change around isolated colonies</p>

1/100
Looks like no tags are added yet.
Name | Mastery | Learn | Test | Matching | Spaced | Call with Kai |
|---|
No analytics yet
Send a link to your students to track their progress
colonization factors
proteins that allow bacteria to colonize in a certain part of the body
fibrin
Makes shield around bacteria preventing phagocytosis
virulence factor
biofilms
communities of bacteria that take in and share nutrients
play a role in chronic infections
Virulence factor
biofilm immune response blockers
requires adhesion and colonization proteins
examples of biofilms
dental plaque on teeth or algae in swimming pools
hemolysis
lyse red blood cells
toxins
bacteria that release poisons and destroy tissue
c. diff uses which toxins
toxin a and b
m proteins
similar to host cell proteins which help bacteria evade phagocytosis
coagulases
enzyme that produces fibrin from fibrinogen at the site of infection; clot offers protection from phagocytosis

coagulases can be identified by
clumping on tests
capsule
glycocalyx that surrounds the bacteria cell and prevents phagocytosis
DNAse
lyses DNA, allows DNA to escape neutrophils spit out DNA nets
positive DNAse test will look like
a clear zone around a streak of bacteria (yellow overtakes the agar)
where do you need to look for hemolysis?
isolated colonies
leukocydins
lyse white blood cells
gamma hemolysis
no change around isolated colonies
alpha hemolysis
brown or green coloring around colonies, but not a full lyse

beta hemolysis
complete lysis of RBCs which leaves a yellow hue

plasma
liquid portion of blood
white blood cells
involved in immune health
platelets
involved in blood clotting
red blood cells
involved in carrying oxygen
when would a white blood count indicate infection
greater than 10,000/μl
plasma %
55%
red blood cell %
45%
neutrophils
eat bacteria; high numbers indicate local bacterial infection
neutrophil looks
multi lobe

lymphocytes
T and B cells; high numbers suggest intracellular viral infection and low numbers indicate HIV
lymphocyte looks
unilobe

eosinophils
high numbers indicate allergic reactions or parasitic infections
eosinophil looks
horseshoe with some granules

basophil looks
thick nucleous very grainy

ABO stand for
sugar molecules on RBC surfaces
should you give a patient an antigen that they don't already have?
no
a blood specs
has a antigens, has anti-b antibodies, can receive a or o blood
b blood specs
has b antigens, has anti-a antigens, can receive b or o blood
ab blood specs
has a and b antigens, has no antibodies, can have any blood
o blood specs
has no antigens, has a and b antibodies, can receive only o blood
universal donor
type o- blood
universal receiver
type ab+ blood
how is blood type determined?
anti-sera testing will cause antibody-mediated crosslinking of cells and agglutination
clumping in a blood test shows
antigens present
if someone has the D antigen they will be what?
Rh positive
is Rh factor natural?
no, you develop IgG after first exposure
is Rh factor genetically determined?
yes, DD is dominant
fetal-maternal incompatibility
the mother's Rh status does not match the baby's so mom produces antibodies against baby
are a and b antibodies natural?
yes, they are IgMs
can Rh + patients receive Rh - blood
yes
PCR
test for the presence or absence of a gene using restriction enzyme or endonuclease
DNA fingerprinting
comparing the difference of isolates which tells us if its from the same source or not
primers for PCR
each products requires two individual primers using restriction enzyme or endonuclease
mecA gene presence means
methicillin resistance
DNA fingerprinting (PFGE) commonly used for
common sourcing
catalase negative means
strep
catalase postive means
staph
coagulase positive means
staph aureus
coagulase negative means
other staph
kirby bauer assay
tests for antibiotic sensitivities
alpha hemolysis optochin sensitive means
strep pneumoniae
alpha hemolysis optochin resistant means
viridans strep
beta hemolysis group a means
group a strep; pyogenes
beta hemolysis group b means
group b strep; newborns
gamma hemolysis means
enterococcus
selective media
prevents some type of bacteria from growing
differential media
distinguishes bacteria by using some visual marker; does not inhibit growth
MSA (mannitol salt agar) type of media
both: selects for salt, but differentiates mannitol fermentors
MacConkey Agar type of media
both: selects for gram negatives, but differentiates lactose fermentors
in which quadrant can you find transient bacteria?
first quadrant
in which quadrant can you find normal flora?
quad 2, 3, and 4
bubbles on a catalase test means
presence of catalase, positive test
a coagulase-positive test will present with what?
agglutination (clumps)
pathogens contain many
antigens
antigens
specific components of a pathogen that are recognized by your immune system
antibodies
recognize and bind to antigens
how do antibodies bind?
the epitope (nucleotide sequence)
good reasons to use an ELISA
- pathogen cannot grow on a plate
- an asymptomatic disease
- sensing antibodies from a previous illness
direct ELISA
detecting a pathogen (is this antigen currently in your body?)
indirect ELISA
detecting antibodies (did you form these from having an illness?)
further test for positive ELISA HIV screening
PFGE or Western Blot
strep pyogenes causes
strep throat, scarlet fever, rheumatic fever
a positive strep test will show
a line on the test section; give antibiotics
strep pyogenes is sensitive to what?
bacitracin
first step of a blood culture
identify the bacterial pathogen
primary medias for identifying pathogens
sheep blood, macconkey, chocolate, TSA
fastidious organisms
those that require many growth factors (chocolate)
identifying E. coli
gram-negative, + lactose fermentor
identifying pseudomonas
gram-negative, non lactose fermentor, blue fluorescent pigment with fruity odor
identifying proteus
gram-negative, non lactose fermentor, oxidase negative, swarming positive
identifying staph aureus
gram-positive, catalase positive, coagulase-positive
identifying strep pyogenes
gram positive, catalase negative, beta hemolysis, group a +
identifying enterococcus
gram- positive, catalase-negative, gamma hemolysis
for stool cultures non lactose fermenting is ...
BAD
hektoen enteric agar type of media
both: selective for gram negative rods, but differentiates lactose fermentors
non lactose fermentors differential in HTA
shigella is pale green while salmonella is black centered
blood agar media type
just differential
TSA agar type of media
none, grows everything
parasitic infection generally manifest as
gastrointestinal infections
What is the purpose of a hemolysis test
to look for lysis of Red Blood Cells
community MRSA
Mec A gene present
Pvl gene present
give antibiotics other than vancomycin